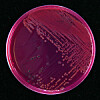

UTVALGTE STILLINGER:
-
PhD Research Fellowship: Exploring how prison affects prisoners health and wellbeing
Deadline: 04.06.2026
-
Direktør for Havdivisjonen
Søknadsfrist: 18.05.2026
-
Forskningsansvarlig
Søknadsfrist: 19.05.2026
-
Avdelingsleder ved Læringsmiljøsenteret (Avd. Porsgrunn)
Søknadsfrist: 10.05.2026
-
PhD Fellowship in Communication and Leadership
Deadline: 01.06.2026
-
Professor / førsteamanuensis i regnskap og bedriftsøkonomiske fag
Søknadsfrist: 31.05.2026
-
Førsteamanuensis / førstelektor innen regnskap og bedriftsøkonomiske fag
Søknadsfrist: 31.05.2026
Annonse
Annonse
Annonse
Annonse
Annonse